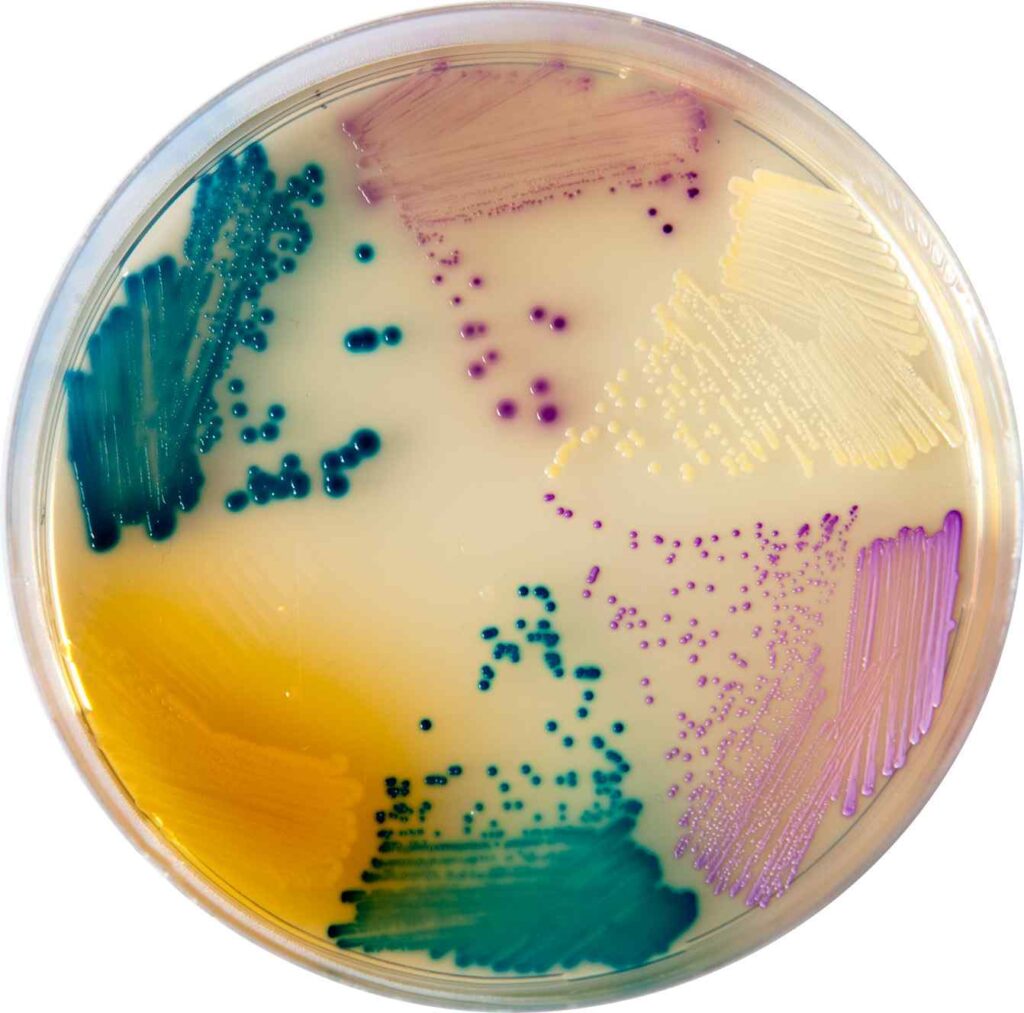

1. INTRODUCTION TO CHROMAGAR
CHROMagar is a powerful and innovative chromogenic culture medium used in microbiology for the easy identification of various microorganisms. The main benefit of CHROMagar lies in its ability to display different microbes in different colors based on their enzymatic activities. This makes CHROMagar very helpful in clinical, industrial, and research settings where quick and reliable identification is important. By simplifying complex procedures, It saves time and resources, making it a preferred choice for many microbiologists. It’s efficiency and visual clarity help even non-experts interpret microbial results accurately.
SUMMARY
- It is a chromogenic culture medium that identifies microorganisms through distinct colony colors for quick and accurate detection.
- It includes essential nutrients, chromogenic substrates, and selective agents to support and differentiate specific microbes.
- It is widely used in clinical diagnostics, food and water testing, and microbiological research for efficient microbial identification.
Table of Contents
2. COMPOSITION

CHROMagar is carefully formulated with specific ingredients that promote the growth of certain microbes while preventing others from growing. Each component in CHROMagar plays a vital role in ensuring selective and differential results. The main ingredients of CHROMagar include:
- Peptones: These provide proteins and nutrients needed for the growth of microorganisms.
- Agar: Acts as a solidifying agent, turning the liquid medium into a gel-like texture.
- Salts: Maintain the osmotic balance and provide essential ions for microbial metabolism.
- Chromogenic substrates: These are the core elements of CHROMagar, which react with microbial enzymes to produce specific colored colonies.
- Selective agents: These include antibiotics or inhibitors that suppress the growth of unwanted bacteria or fungi.
Different types of CHROMagar are designed for different microbes. For instance, CHROMagar Candida is specially made to grow and identify Candida species like Candida albicans, Candida tropicalis, and others by producing distinct colony colors. These targeted formulas make CHROMagar highly effective for a wide variety of clinical and environmental testing purposes.
3. PRINCIPLE
The working principle behind CHROMagar is known as chromogenic differentiation. In simple terms, it contains special color-producing compounds (chromogen) that interact with enzymes found in specific microorganisms. When these enzymes break down the chromogens, they produce colorful compounds that remain in the microbial colonies. Each microbe produces a unique color based on the type of enzyme it has.
For example, when using CHROMagar Candida:

- Candida albicans forms green-colored colonies.
- Candida tropicalis appears as metallic blue colonies.
- Other Candida species show different colors, allowing easy identification.
This principle of CHROMagar allows multiple microbes to be detected on a single plate, all distinguished by their colony color. It eliminates the need for complicated biochemical tests, making CHROMagar an efficient tool for both professionals and students.
4. PREPARATION
Preparing CHROMagar in the lab is simple if standard procedures are followed. Here’s how to make CHROMagar:
- Accurately weigh the CHROMagar powder according to the manufacturer’s guidelines.
- Mix the powder with distilled water in a clean container.
- Heat the mixture gently while stirring continuously to dissolve the powder completely.
- Autoclave the solution at 121°C for 15 minutes to sterilize it.
- Allow the sterilized CHROMagar to cool down to around 45–50°C.
- Pour the medium into sterile Petri dishes and let it solidify.
- Store the solid CHROMagar plates in the refrigerator for later use.
It is important to avoid overheating or reheating the medium, as this may damage the chromogenic components and affect the quality of the CHROMagar. Proper preparation is key to getting accurate results when using CHROMagar.
5. RESULTS INTERPRETATION
After a sample is inoculated onto CHROMagar and incubated, typically for 18–24 hours at the appropriate temperature, distinct colored colonies appear. These colors help microbiologists quickly identify the organisms. CHROMagar makes it possible to:
- Identify multiple organisms on the same plate.
- Differentiate species based on color, shape, and size of colonies.
- Avoid the need for additional biochemical tests.
For example, on CHROMagar Orientation (used for urine cultures):
- Escherichia coli shows pink to reddish colonies.
- Proteus species form brown colonies with a halo.
- Enterococcus may appear as turquoise colonies.
By simply observing the color and appearance of the colonies, CHROMagar provides rapid and clear identification of microbes. This visual feedback allows for quicker treatment decisions in clinical settings and faster contamination tracking in environmental studies.
6. USES OF CHROMAGAR
CHROMagar has many important uses in various fields of microbiology due to its efficiency and accuracy. Here are some of the major applications of CHROMagar:
- Clinical Diagnostics: CHROMagar helps in quickly identifying pathogens in human samples like urine, blood, stool, sputum, and wound swabs. It is useful for diagnosing infections such as urinary tract infections, yeast infections, and gastrointestinal diseases.
- Hospital Infection Control: CHROMagar is valuable in screening for drug-resistant organisms like MRSA (Methicillin-Resistant Staphylococcus aureus), VRE (Vancomycin-Resistant Enterococci), and ESBL (Extended-Spectrum Beta-Lactamase) producing bacteria.
- Food and Water Testing: CHROMagar is used to check for microbial contamination in food products and drinking water. It ensures the safety and quality of consumables.
- Pharmaceutical and Cosmetic Industry: CHROMagar is used to monitor microbial contamination during the production process.
- Academic and Research Laboratories: Scientists use CHROMagar in studies of microbial diversity, enzymatic behavior, and antimicrobial resistance.
Overall, CHROMagar serves as a versatile and reliable medium for the easy and quick detection of harmful microorganisms. Its simplicity, clarity, and speed make CHROMagar an essential part of microbiology laboratories worldwide.
CONCLUSION
CHROMagar has transformed the way microbiologists identify and differentiate microorganisms. Its color-based identification method saves time, reduces cost, and increases accuracy. CHROMagar is now widely used in hospitals, food industries, water testing labs, and research centers. With its ability to detect multiple organisms on a single plate using color as a guide, CHROMagar continues to play a vital role in public health and laboratory diagnostics.
By offering clear visual results and reliable differentiation, CHROMagar proves to be a top choice for professionals working with microbes. Its user-friendly approach, combined with precision, makes CHROMagar a must-have tool in modern microbiology.
Frequently Asked Questions (FAQs)
What is CHROMagar and how does it help in identifying microorganisms?
CHROMagar is a special type of culture medium used in laboratories to grow and identify bacteria and fungi. It contains color-producing chemicals that react with specific microbes. When the microbes grow on the plate, they form colonies in different colors. This helps scientists easily recognize which microbe is present just by looking at the color.
How do different types of CHROMagar media work for microbial detection?
There are different types of CHROMagar made for different microbes. For example, CHROMagar Candida helps detect types of yeast, while CHROMagar MRSA is used to find drug-resistant bacteria. Each type contains specific ingredients that support the growth of target organisms and produce distinct colors to tell them apart. This helps identify multiple organisms quickly and clearly.
What are the main uses and benefits of CHROMagar in clinical and food microbiology?
CHROMagar is used in hospitals to detect infections, like urinary tract infections or drug-resistant bacteria. It is also used to check food and water for harmful microbes. The main benefits of CHROMagar are that it gives fast results, is easy to use, and makes it simple to spot different microbes using colors. This saves time and helps with quick decisions in healthcare and food safety.
Related Articles